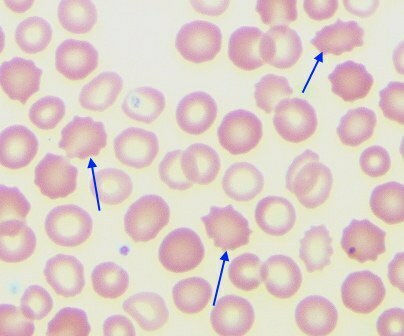
The discovery of corpuscles and globular particles

-
In 1658, The Dutch naturalist, Jan Swammerdam, saw what he described as oval red blood corpuscles. He also discovered a frog embryo has globular particles.
In 1658, The Dutch naturalist, Jan Swammerdam, saw what he described as oval red blood corpuscles. He also discovered a frog embryo has globular particles. -
 In 1665, Robert Hooke used his knowledge and previously newly founded information to write a book. He published "Micrographia". This was a knowledge filled book completely devoted to microscopical observations
In 1665, Robert Hooke used his knowledge and previously newly founded information to write a book. He published "Micrographia". This was a knowledge filled book completely devoted to microscopical observations -
 Microorganisms were discovered by Antoni van Leeuwenhoek. Antoni saw motile particles under his microscope and assumed they equated to life. He then wrote a letter to the royal society that those particles were living organisms.
Microorganisms were discovered by Antoni van Leeuwenhoek. Antoni saw motile particles under his microscope and assumed they equated to life. He then wrote a letter to the royal society that those particles were living organisms. -
 The Scottish Botanist, Robert Brown, made an extremely important discovery. He was the first to recognize the nucleus, to which he described as an essential constituent of living cells.
The Scottish Botanist, Robert Brown, made an extremely important discovery. He was the first to recognize the nucleus, to which he described as an essential constituent of living cells. -
 The botanist, Matthias Jakob Schleiden, suggested that all plants are composed of cells or their products. The following year, a zoologist of the name of Theodor Schwann came to a similar conclusion, but for animals.
The botanist, Matthias Jakob Schleiden, suggested that all plants are composed of cells or their products. The following year, a zoologist of the name of Theodor Schwann came to a similar conclusion, but for animals. -
 In 1865, Karl Deiters published posthumously. This book contained descriptions and drawings of nerve cells. Which all were studied by using histological methods.
In 1865, Karl Deiters published posthumously. This book contained descriptions and drawings of nerve cells. Which all were studied by using histological methods. -
 In 1870, the oil immersion lens was introduced. Microscopy was improved due to the development of the microtone technique, the use of new fixing methods, and dyes.
In 1870, the oil immersion lens was introduced. Microscopy was improved due to the development of the microtone technique, the use of new fixing methods, and dyes. -
 In 1872, the German Histologist, Joseph Gerlach, proposed that in all nervous systems , nerve cells establish anastomoses with each other through branching of their dendrites.
In 1872, the German Histologist, Joseph Gerlach, proposed that in all nervous systems , nerve cells establish anastomoses with each other through branching of their dendrites. -
 To what is said is the most important breakthrough in neurocytology and neuroanatomy were developed by Golgi. Golgi developed the "black reaction" The reaction provided a full view of a single nerve cell and its processes. In which it was followed through a great distance from the cell body.
To what is said is the most important breakthrough in neurocytology and neuroanatomy were developed by Golgi. Golgi developed the "black reaction" The reaction provided a full view of a single nerve cell and its processes. In which it was followed through a great distance from the cell body. -
 Observations by Walther Flemming concluded to what is called "chromatin". Within the nucleus, a stainable substance and the nucleus can be seen. The structures that could be heavily stained are called "Chromatin". Walther also introduced the world to the term Mitosis in the same year, In which he observed the splitting of salamander chromosomes.
Observations by Walther Flemming concluded to what is called "chromatin". Within the nucleus, a stainable substance and the nucleus can be seen. The structures that could be heavily stained are called "Chromatin". Walther also introduced the world to the term Mitosis in the same year, In which he observed the splitting of salamander chromosomes.
Looking for a timeline maker?
Create timelines for projects, roadmaps, history, lessons, legal cases, and stories with Timetoast. Timetoast is a timeline maker for work, school, research, and stories.